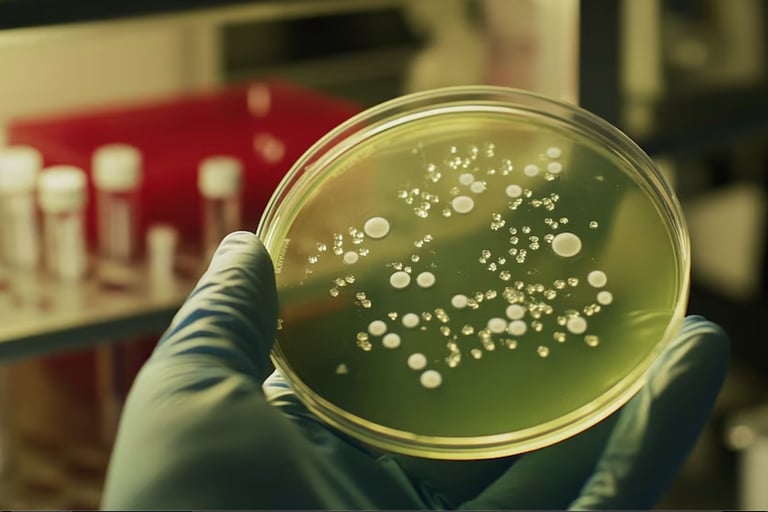
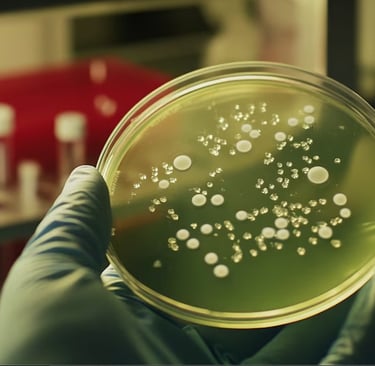

Qué relación hallaron entre una bacteria intestinal y la fuerza muscular de los adultos mayores
Científicos analizaron muestras de distintas edades y evaluaron su desempeño físico. El hallazgo abre nuevas perspectivas para el desarrollo de probióticos orientados a preservar la vitalidad.


Un grupo de investigadores de Europa detectó que la presencia de la bacteria Roseburia inulinivorans podría estar vinculada a un mejor desempeño muscular. Los resultados de la investigación fueron publicados en la revista especializada Gut.
Para hacer el trabajo, los científicos analizaron muestras de adultos jóvenes y mayores que residen en Países Bajos y España.
Secuenciaron el ADN de bacterias presentes en materia fecal y observaron que solo la presencia de la bacteria Roseburia inulinivorans mostró una relación clara con mejores resultados en pruebas de fuerza, como la prensión manual y los ejercicios de piernas y banca.
Es decir, quienes tenían más cantidad de esta bacteria solían mostrar más fuerza, aunque esto no demuestra una causa directa.

En el futuro, se podría explorar el uso de esa bacteria como probiótico para frenar la pérdida de músculo con la edad, aunque los investigadores aclararon que aún no existen pruebas suficientes para asegurar ese beneficio en la vida diaria.
El equipo estuvo formado por especialistas de centros de Países Bajos, España y Alemania, como el Centro Médico Universitario de Leiden, la Universidad de Granada y el Laboratorio Europeo de Biología Molecular.
El objetivo de los científicos fue averiguar si ciertas bacterias del intestino están vinculadas a la fuerza muscular.
Para eso, analizaron muestras de 90 jóvenes entre 18 y 25 años y 33 adultos mayores de más de 65.
Además, midieron la fuerza de prensión manual, el rendimiento en ejercicios de piernas y banca, y el consumo máximo de oxígeno. Solo la bacteria Roseburia inulinivoransmostró una asociación positiva con la fuerza.
En los mayores, quienes tenían esta bacteria mostraron un 29% más de fuerza de prensión manual respecto a quienes no la tenían, aunque esto no se reflejó en el consumo de oxígeno.
En jóvenes, una mayor cantidad de Roseburia inulinivorans coincidió tanto con más fuerza como con mejor capacidad cardiorrespiratoria.
No todas las personas tienen esta bacteria en igual cantidad. El estudio mostró que es más abundante en jóvenes, donde puede llegar hasta el 6,6% de las bacterias del intestino, y menos frecuente en adultos mayores, con un máximo de 1,3%.
Según los datos, su abundancia parece disminuir con el avance de la edad, un periodo durante el cual la prevalencia de la sarcopenia aumenta.
Pruebas con ratones y preguntas sin respuesta
Para saber si esta bacteria podría mejorar la fuerza muscular, los investigadores también hicieron pruebas en ratones. Después de reducir su microbiota con antibióticos, les dieron diferentes especies de Roseburia.
Solo los ratones que recibieron Roseburia inulinivorans aumentaron la fuerza de sus patas delanteras en un 30% después de unas semanas.
Estos ratones también tuvieron fibras musculares más grandes y un mayor número de fibras rápidas.
Pero hay que tener en cuenta algo importante: ninguna de las bacterias humanas logró establecerse de manera estable en los ratones, lo que hace pensar que los efectos podrían haber sido pasajeros.
Además, no se estudiaron a fondo los mecanismos de inflamación o de comunicación entre nervios y músculos, que pueden ser claves en esta relación.
Los investigadores señalaron: “Se necesitan estudios longitudinales para determinar si los cambios en la abundancia de Roseburia inulinivorans son causa o consecuencia de las mejoras en la función muscular”.
El hallazgo es prometedor, pero no definitivo. La asociación entre la bacteria y la fuerza muscular se observó en grupos pequeños y aún no hay ensayos en humanos en los que se administre la bacteria para comprobar si realmente mejora la fuerza.
Tampoco se controlaron factores como la dieta, la actividad física o los medicamentos, que pueden cambiar tanto la microbiota como el músculo.
Además, el uso de antibióticos en ratones antes de darles Roseburia inulinivorans puede generar cambios artificiales en el intestino, por lo que los resultados no se pueden aplicar directamente a las personas.
Para los científicos, la bacteria Roseburia inulinivorans “emerge como un modulador específico de la fuerza muscular, vinculando la microbiota intestinal con el metabolismo y la función del músculo”.
La recomendación es seguir investigando, porque todavía falta mucho para saber si ese microorganismo realmente puede marcar la diferencia en la fuerza muscular humana.
En diálogo con Infobae, la doctora Silvia Sookoian, investigadora superior del Conicet, médica hepatóloga y decana de la Facultad de Ciencias de la Salud de la Universidad Maimónides (UMAI) en Buenos Aires señaló: “El nuevo hallazgo publicado en la revista Gut refuerza la idea de que algunas bacterias pueden tener una acción beneficiosa en el ecosistema del cuerpo humano. En este caso, estaría asociada a la fuerza muscular".
En la actualidad -contó- algunas bacterias del género Roseburia están siendo evaluadas como parte de los probióticos de próxima generación. Su uso podría modular simultáneamente condiciones sistémicas, como las enfermedades cardiovasculares y metabólicas.
“El nuevo trabajo se concentra en Roseburia inulinivorans. Está hecho en una población muy chica de pacientes. La validación experimental está hecha en roedores. Por eso, por el momento sirve más como prueba de concepto que como evidencia robusta de causa-efecto", concluyó Sookoian.


